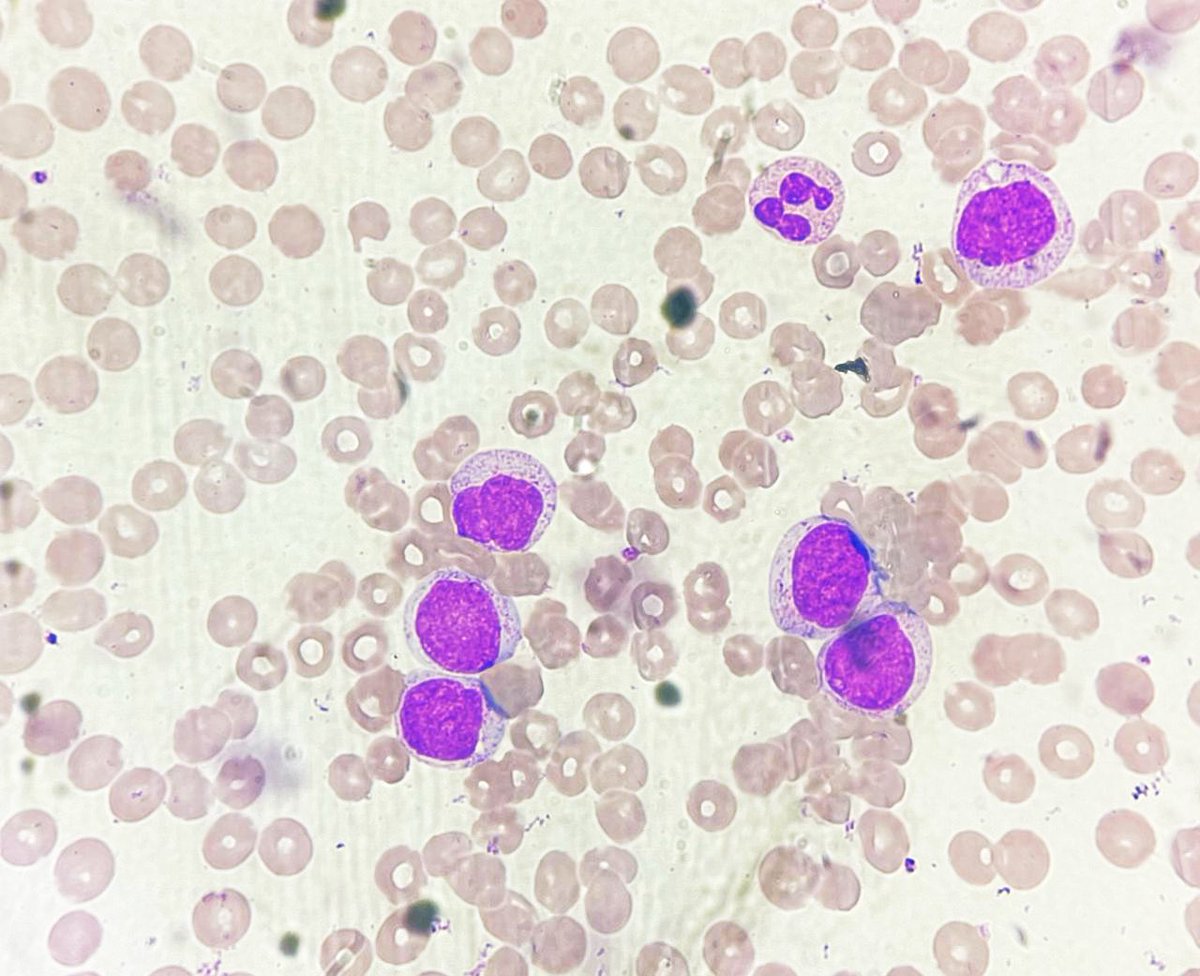
NidhinMd's tweet image. 26 year old male with fever and generalised weakness for 05 days presents with a total leukocyte count of 88,500. He is supposed to get married next week! #PathTwitter #twitterpath #pathresident #pathology #hematology #hematopat #hemepath #diagnosis #leukemia
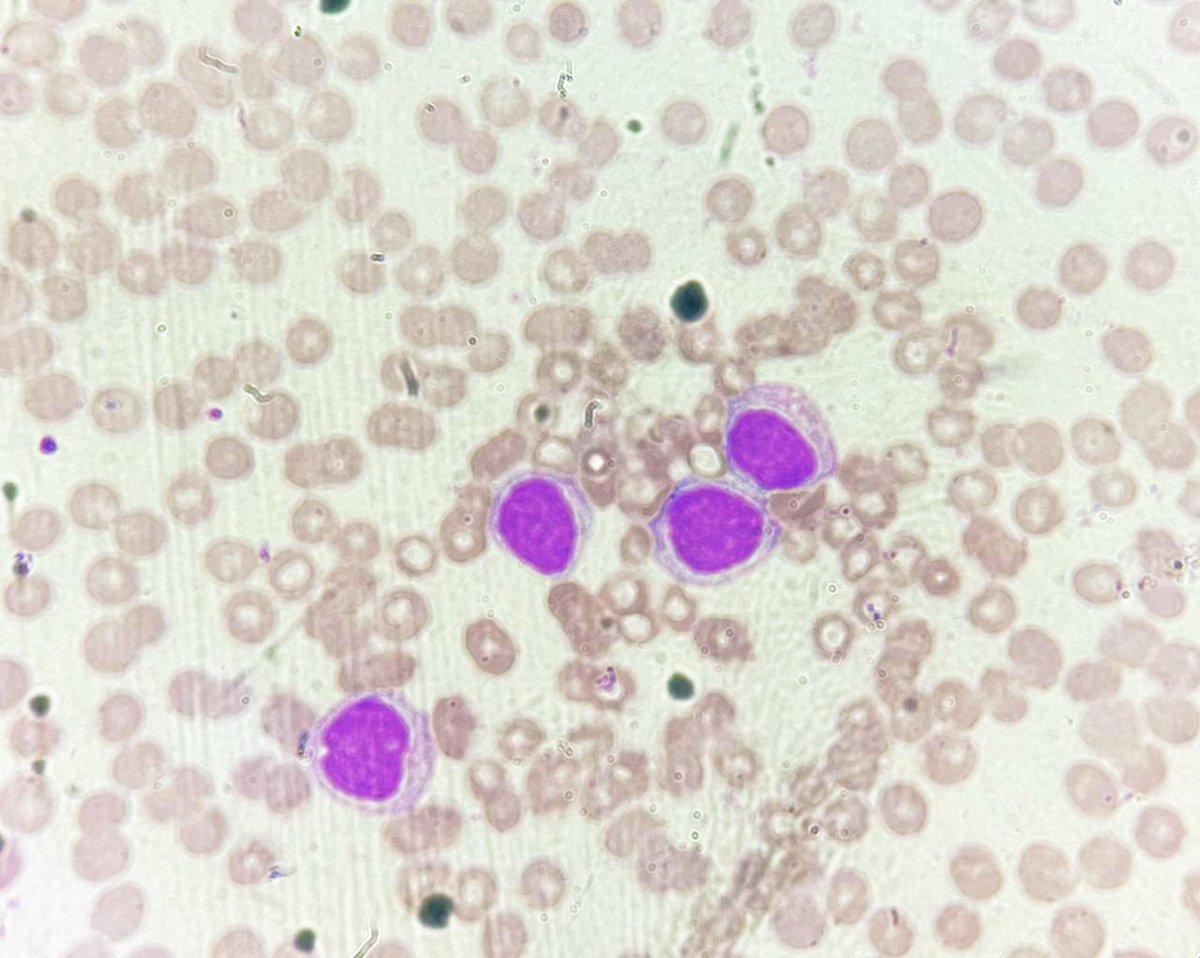
NidhinMd's tweet image. 26 year old male with fever and generalised weakness for 05 days presents with a total leukocyte count of 88,500. He is supposed to get married next week! #PathTwitter #twitterpath #pathresident #pathology #hematology #hematopat #hemepath #diagnosis #leukemia
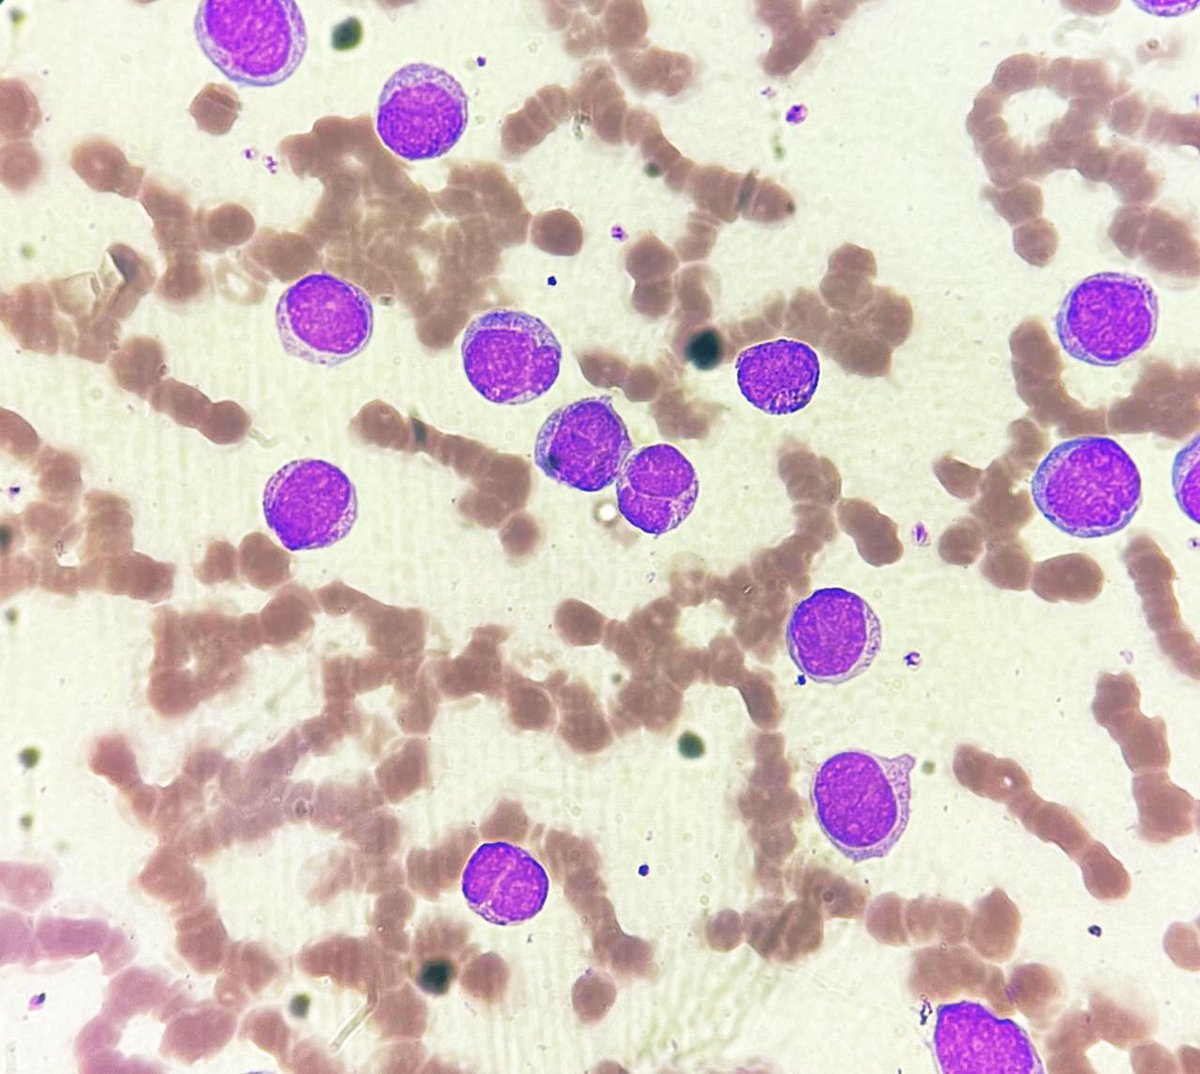
NidhinMd's tweet image. 26 year old male with fever and generalised weakness for 05 days presents with a total leukocyte count of 88,500. He is supposed to get married next week! #PathTwitter #twitterpath #pathresident #pathology #hematology #hematopat #hemepath #diagnosis #leukemia
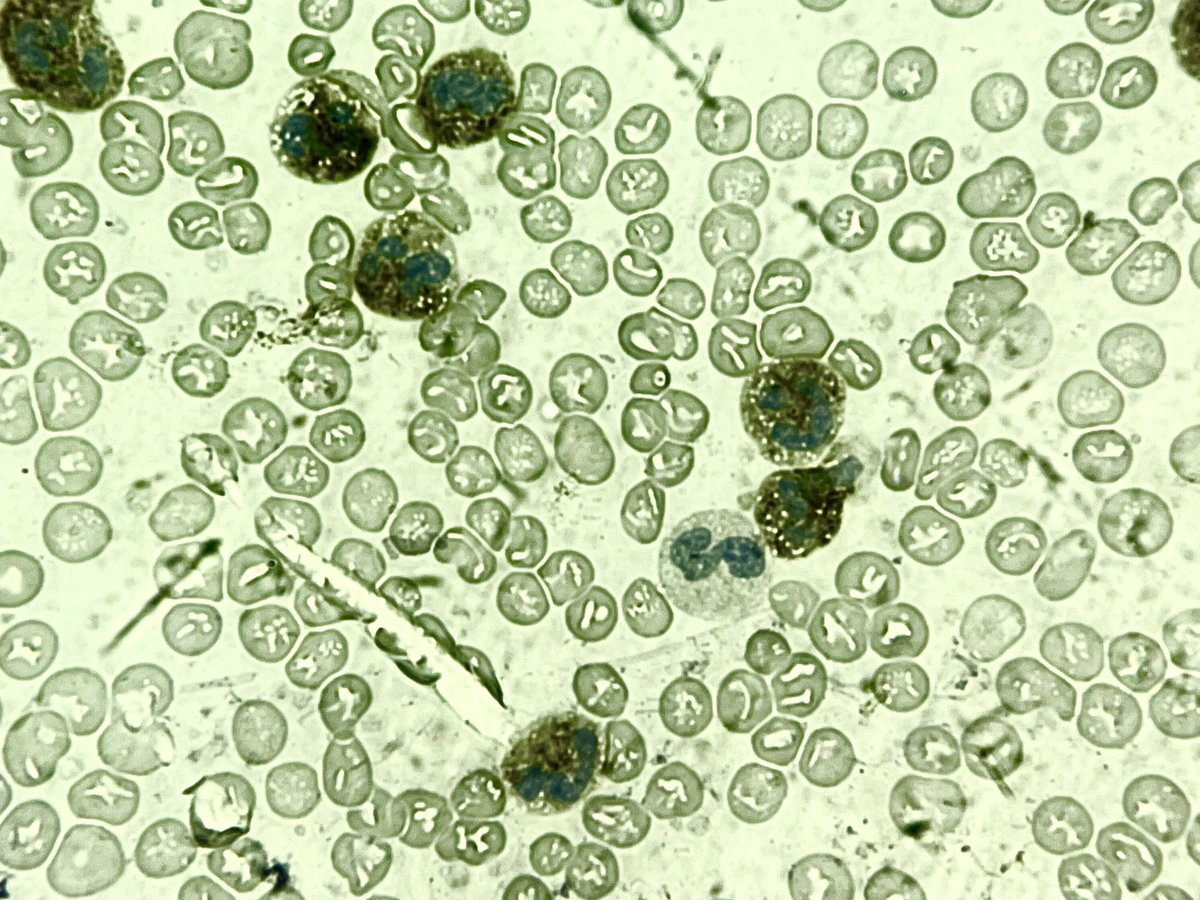
NidhinMd's tweet image. How much will you score this LAP? #PathTwitter #twitterpath #pathresident #hemepath #hematology #hematopath
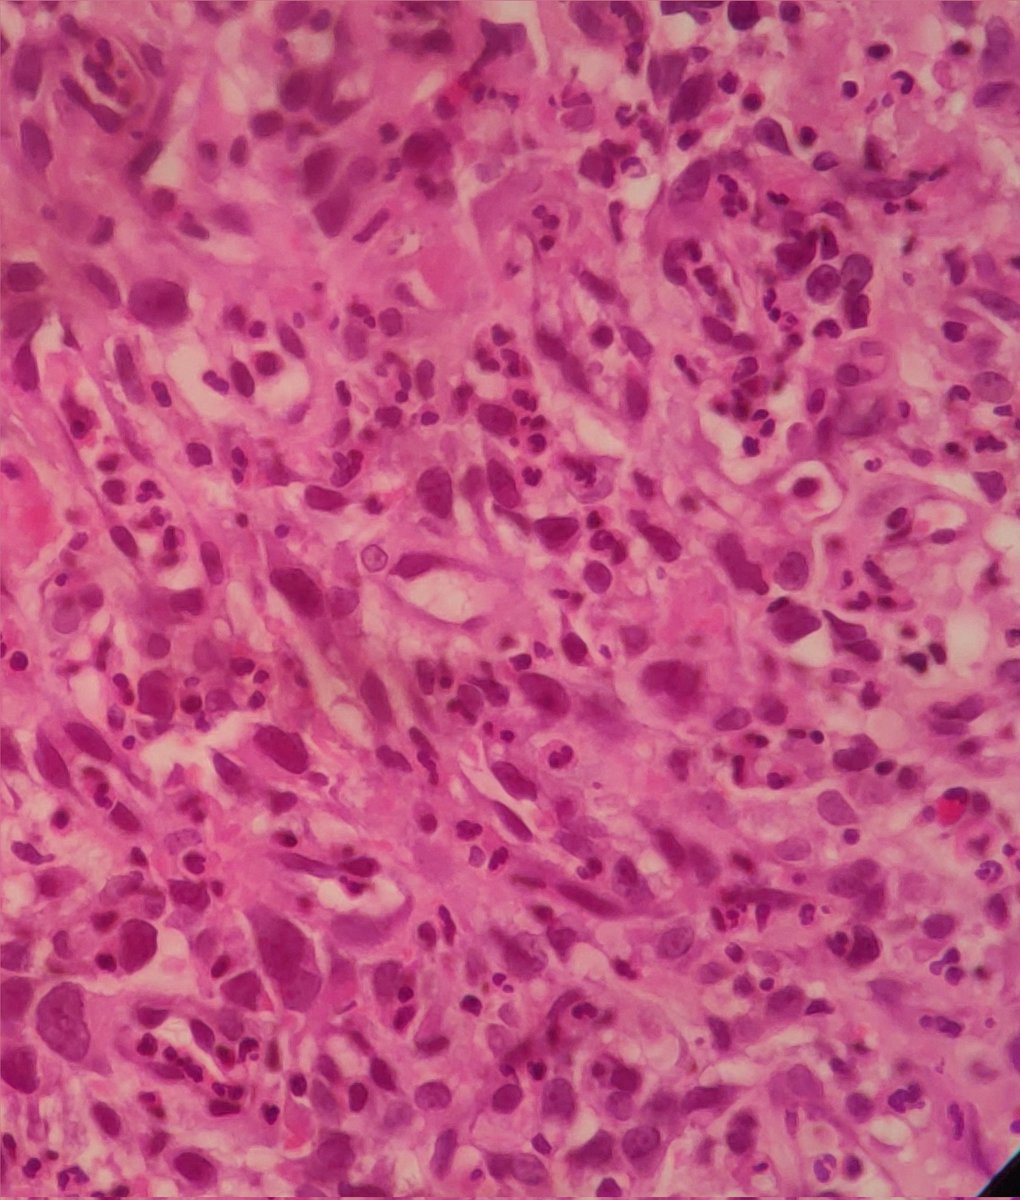
joemdoc's tweet image. Hey #twitterPath, 85/F. Gastric Fundal Mass
What's the diagnosis here?
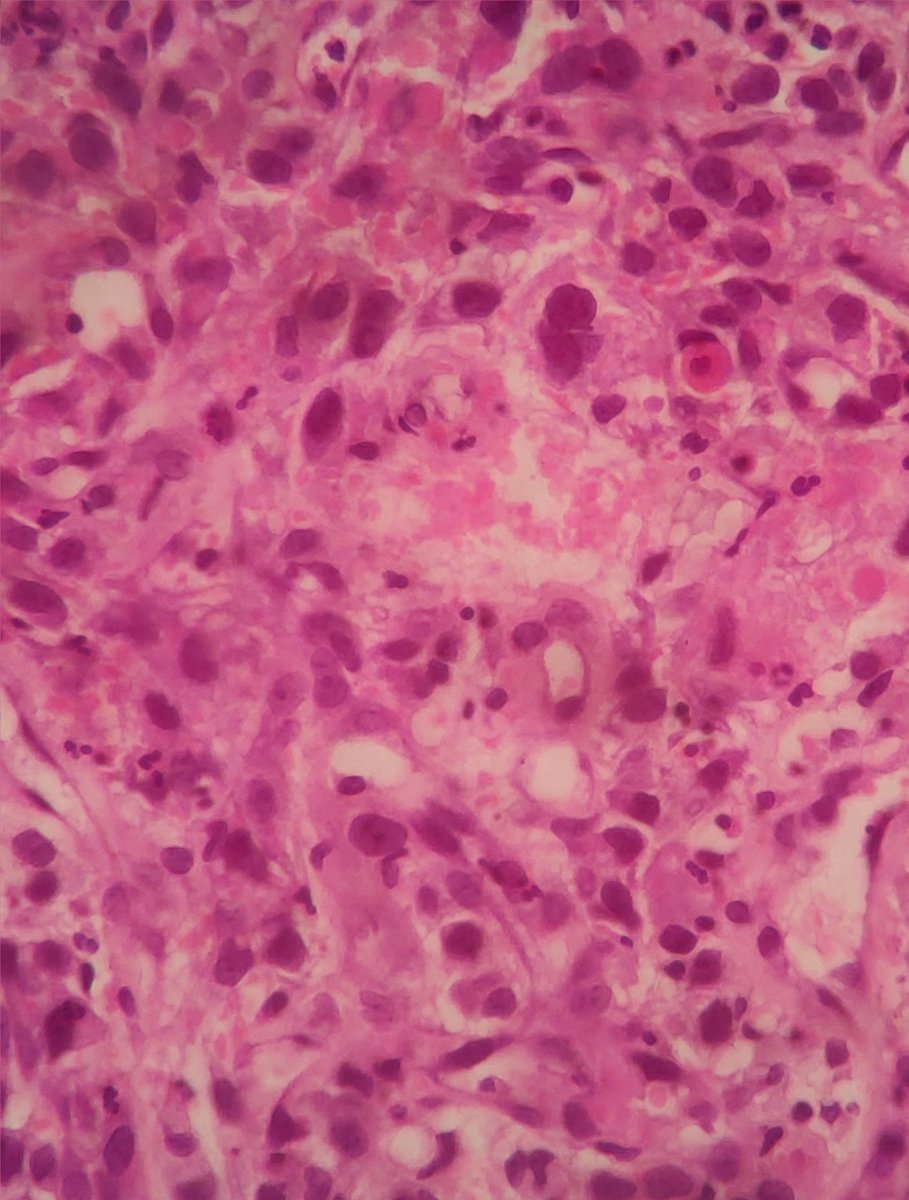
joemdoc's tweet image. Hey #twitterPath, 85/F. Gastric Fundal Mass
What's the diagnosis here?

#twitterpath search results
Just discovered that my mother thinks ‘Cytology’ is looking only at cytoplasm. My mom thinks I’ve been just looking at free floating cytoplasm for months now. #twitterpath #pathtwitter #pathology #cytology @UTMB_Pathology
Cartilaginous lesion. Entrapment or encasement?🤔 #BSTPath #pathology #twitterpath #residentspath #digipath


First case of 2023.🥳🥳 35 years female swelling over right maxillary region. 😯 What am I? 🤔 #TwitterPath #PathTwitter #OralPathology #MedTwitter

Incidental cute finding of the day. Station lymph node. H&E tells you the story even before you dig into EMRs. 😆🔬 Think I saw this finding first through #TwitterPath about a year ago (or was it even before that? Please correct me @smlungpathguy if I am wrong 😆).


Inflammatory fibroid polyp of the gastric antrum. An extremely rare entity that represents 0.1% of gastric polyps. This was localized in the gastric antrum of a 72 year old woman. #pathology #twitterpath




40 yo female with vaginal hemorrhage and a protruding mass from the uterine cervix. #pathology #twitterpath



#renalpath #twitterPath #IHC #histopathology #pathology #thrombospondin The perinuclear "dot" positivity for Thrombospondin in normal visceral epithelial cell cytoplasm.. serves a good internal control to check adequacy of staining!!

#renalpath #askrenal #TwitterPath #electronmicroscopy #ultrastructure @askrenal Subepithelial spherules: enigmatic structures resembling viral particles.. possibly derived from visceral epithelial cell cytoplasm. Any thoughts on origin & significance?




Excited to be a part of CAP23 in Chicago! @Pathologists #Pathology #TwitterPath #LoveForPath #Path2Path #Network #Exhibits #Education
26 year old male with fever and generalised weakness for 05 days presents with a total leukocyte count of 88,500. He is supposed to get married next week! #PathTwitter #twitterpath #pathresident #pathology #hematology #hematopat #hemepath #diagnosis #leukemia

📌Apocrine CA, breast ➡️Tumor cells have distinct cell margins, abundant acidophilic cytoplasm with eosinophilic granules, central to eccentric nuclei with prominent nucleoli ➡️Similar/ slightly better prognosis as inv ductal ca ➡️Mostly triple negative #TwitterPath #MedTwitter

A formal, international, multi-institutional pathology study was initiated and coordinated entirely online via Twitter #EBUSTwitter Full @ArchivesPath article here: doi.org/10.5858/arpa.2… @smlungpathguy @lara_pijuan #twitterpath #SoMe

A keratin pearl of a Seb K being torn apart during processing. #pathology #twitterpath #dermpath #pathart


3 year old male, cystic swelling left ear. ⁉️Solid nests of basaloid cells undergoing abrupt trichilemmal-type keratinization ❓️What am I? #PathTwitter #TwitterPath #AnatomicPathology

New Publication rdcu.be/e38PP Clinicopathological Spectrum of Head and Neck Mucoepidermoid Carcinoma: A Three-case Series #springerpublication #headandneck #twitterpath
Bladder mass , different biopsies in the background of bilharzial cystitis #pathology #GUpath #twitterpath




This is gorgeous! #RenalPath #TwitterPath #XPath
Thanks Dr Vijay. I look forward to re-engaging on sharing and discussing with you et al interesting case on #TwitterPath 🤗
Happy to share this intriguing case of EBV+ cutaneous extranodal NK/T lymphoma that showed a really indolent behaviour: another confirmation of how unpredictable cutaneous lymphomas can be! #hemepath #twitterpath
Wait and see: a case of EBV + cutaneous extranodal NK/T-type lymphoma with indolent behaviour dlvr.it/SxqwfW
link.springer.com
Wait and see: a case of EBV + cutaneous extranodal NK/T-type lymphoma with indolent behaviour
Virchows Archiv - Extranodal NK/T-cell lymphoma (ENKTL) is a rare lymphoma subtype associated with Epstein-Barr virus (EBV) infection, portending a poor prognosis despite systemic chemotherapy. We...
Excited to be a part of CAP23 in Chicago! @Pathologists #Pathology #TwitterPath #LoveForPath #Path2Path #Network #Exhibits #Education
In Palm Springs California; getting ready to show cases for USCAP Interactive Microscopy Sessions. #USCAP #twitterpath #pathology @LSUHS

💊45 years old, female 💉 FNAC Thyroid ☢️ TIRADS V Lesion on Ultrasound. #TwitterPath #MedTwitter #SurgicalPathology #Histopathology #Thyroid

🐥Early Bird Registration Ends Aug 31st!🐥 Don't miss your chance to register for an exciting time at the OAP Annual Conference! 🧬🔬 #TwitterPath ontariopathologists.org/oap-events/oap…
3 year old male, cystic swelling left ear. ⁉️Solid nests of basaloid cells undergoing abrupt trichilemmal-type keratinization ❓️What am I? #PathTwitter #TwitterPath #AnatomicPathology

Eyelid metastasis as the initial presentation of Renal cell carcinoma. 59 y/o M presented with a fast growing ulcerated nodule on the upper eyelid. Clinically chalazion or pyogenic granuloma. #twitterpath #Pathology


40 yo female with vaginal hemorrhage and a protruding mass from the uterine cervix. #pathology #twitterpath



Can a gross specimen give a more obvious diagnosis? Pelvic lymph node mass in a 55 year old #twitterpath #PathTwitter # #pathresident #grosspath #diagnosis #histopathology

A rare case of chordoma of the base of the skull/clivus presenting as nasopharyngeal mass. No brachyury antibody available. #pathology #twitterpath


Adrenal mass, gross diagnosis? #twitterpath #PathTwitter #pathresident #pathology #grosspath #diagnosis

💊45 years old, female 💉 FNAC Thyroid ☢️ TIRADS V Lesion on Ultrasound. #TwitterPath #MedTwitter #SurgicalPathology #Histopathology #Thyroid

Inflammatory fibroid polyp of the gastric antrum. An extremely rare entity that represents 0.1% of gastric polyps. This was localized in the gastric antrum of a 72 year old woman. #pathology #twitterpath




📌Rheumatoid nodule Fibrin deposition & necrobiosis is often seen in center of nodule surrounded by well developed palisading of histiocytes, granulation tissue, lymphs, plasma cells, eosinophils, variable giant cells, fibrosis, occ giant cells #TwitterPath #MedTwitter

Bizzare multi nucleated plasma cell in the bone marrow aspirate #PathTwitter #twitterpath #pathresident #pathology #hemepath #hematology

When the mother takes the spotlight! @captmanoj #PathTwitter #twitterpath #pathology #pathresident #lymphnode

28 year old raped, Hyderabad again? 5th such incident in 15 days, I believe. You can expect from a responsible Pinki is just a Tweet from #TweetVeers following just a #TwitterPath

How much will you score this LAP? #PathTwitter #twitterpath #pathresident #hemepath #hematology #hematopath
Spotted this wretched tumour in the endometrium of a poor 60 year old lady #pathology #twitterpath #gynaecpathology

Happy Monday, #TwitterPath universe! Revisit our #FreeAccess supplement, "The Genomic Revolution: The critical role of cytopathology in patient-centered care and personalized medicine" onlinelibrary.wiley.com/toc/19346638/1…

Something went wrong.
Something went wrong.
United States Trends
- 1. ENDLESS LOVE FOR HEESEUNG N/A
- 2. #AlwaysTogetherHEESEUNG N/A
- 3. Good Sunday N/A
- 4. Mueller N/A
- 5. chappell roan N/A
- 6. byers N/A
- 7. Nebraska N/A
- 8. Vandy N/A
- 9. #DMDWORLDinJAPAN N/A
- 10. Whale - Buy N/A
- 11. Acuff N/A
- 12. #Toonami N/A
- 13. High Point N/A
- 14. American English N/A
- 15. #LoveYouTeacherSeriesEP2 N/A
- 16. Sweet 16 N/A
- 17. Arkansas N/A
- 18. Tyler Tanner N/A
- 19. Rob Martin N/A
- 20. Vanderbilt N/A